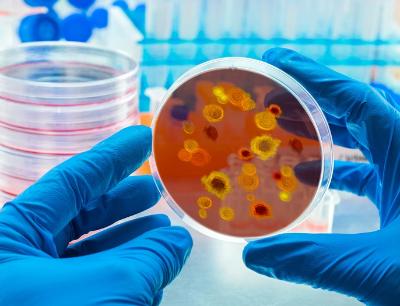

Vergisi bankların boynuna – Mərkəzi Bank çıxış yolunu hələki belə görür
Bu il fevralın 1-dən banklardakı əmanətlərin gəlir faizinə 10 faiz həcmində vergi tətbiq edildi. Bununla bağlı Azərbaycan Mərkəzi Bankının mövqeyi bankları “çox sevindirməsə” də qarşıdakı aylarda bazardakı tendensiyalar müəyyən yeni tənzimləmələrə səbəb ola bilər. Çünki son bir ildə Azərbaycan Mərkəzi Bankının bank sektoruna gətirdiyi yeni tənzimləmə alət və meyarları əslində sistemdə ciddi canlanma yaradıb. Belə deyək ki, bank menecerləri üçün “komfort mühit” bitdi, indi kim nə qədər bacarıqlıdır, elə yaşayacaq.
ENA.az-SUAL
- Azərbaycan Mərkəzi Bankı 2022ci ildə depozitlər üzrə məcburi ehtiyat normasını artırdı. Eyni zamanda, 2023-cü ildən depozitlər üzrə faiz gəlirləri vergiyə cəlb edilir. Və Siz yuxarıda bankların bunu öz depozit faizlərində əks etdirəcəyi ilə bağlı fikirlər səsləndirdiniz. Bu amillər maliyyə resursunun dəyərini artırır və iqtisadi qanunauyğunluğa görə nəticədə kreditlər bahalaşacaq. Halbuki, hökumət kredit faizlərinin aşağı salınması ilə bağlı çağırışlar edir. Bu artımları bazar tənzimləyəcək, yoxsa Mərkəzi Bankın hansısa müdaxiləsi olacaq?
Baş direktor Vüqar Əhmədov:
- Verdiyiniz sual bütövlükdə bankların resurs bazası və onun dəyəri ilə bağlıdır. Məcburi ehtiyat normaları ilə bağlı qərarlar verilərkən əlbəttə, banklardakı resursun dəyərinə necə təsir etməsi ilə bağlı qiymətləndirmələrimizi apardıq. Burada manat və xarici valyuta üzrə öhdəliklərdə təsirlər fərqlidir və bu təsirlər olduqca minimal qiymətləndirilir. Manat öhdəlikləri üzrə bu təsir təxminən 0,16% bəndi səviyyəsindədir. Xarici valyuta üzrə isə 0,01% bəndi təşkil edir. Lakin bütövlükdə Mərkəzi Bankın ehtimalı ondan ibarətdir ki, bu xərclər kredit faizlərinə təsir göstərməyəcək. Çünki kredit faizi bazar əsasında formalaşır və kredit faizlərinin formalaşmasında 4 faktor rol oynayır.
- Faiz xərcləri-resursun dəyəri
- Qeyri-resurs xərcləridir
- Risklər
- Marja
Bankların daxili faiz formalaşdırma siyasəti mövcuddur və onlar rəqabətli şəraitdə faizlərin əhəmiyyətli qalxışını istəmirlər. Biz də ehtimal edirik ki, bu faizlərə artırıcı təsir göstərməyəcək. Bunu statistika da təsdiqləyir. Yeni verilmiş kreditlər üzrə faiz dərəcələrinin dəyişilməz olduğunu görə bilərsiniz. Biz əlbəttə ki, maliyyə bazarlarının təhlilini həyata keçirməkdə davam edəcəyik. Hazırkı dönəmdə əmanət gəlirlərlərinin vergiyə cəlb edilməsinin maliyyə sabitliyi üçün təhdid yaratmadığını və əmanət portfelində hər hansı bir ciddi dəyişikliyin olacağını gözləmirik.
AMB-nin sədri Taleh Kazımov:
- Biz düşünürük ki, banklar həmin xərci öz depozit faizlərində əks etdirəcəklər. Yəni, maliyyə sabitliyi nöqteyinəzərdən çox güman ki, depozitlərin bankdan çıxmaması üçün depozitlərlər üzrə faizlər həmin vergi faizi qədər artırılacaq. Böyük problem görmürük. Ola bilsin ki, kredit faizlərinə təsir edəcək. Bunun qiymətləndirilməsi üçün müəyyən bir vaxt keçməlidir.
Biz məcburi ehtiyat normasını dəyişəndə həmişə qabaqlayıcı amilləri hesablayırıq ki, təsiri necə olacaq. Bazarda rəqabətliliyi nəzərə alsaq həm depozitlərə vergi, həm məcburi ehtiyat normalarının artımı sadəcə bankların marjasına təsir edəcək.
Hansı ki, bugün və keçmişdə də mən qeyd etmişdim ki, mənim qiymətləndirmələrimə görə, marja çox yüksəkdir və orada sıxılmağa yer var. Ona görə də biz kəskin artım gözləmirik.
Vergiyə cəlb olunma ilə bağlı bizə sadəcə bir vaxt lazımdır ki, müşahidələrimizi aparaq. Çünki məcburi ehtiyat normalarını dəyişəndən sonra yeni verilmiş kreditlərdə faizlər dəyişilməyib. Növbəti aylarda da vergiyə cəlb olunma ilə bağlı təsirləri görəcəyik.
Millət vəkili Vüqar Bayramov:
- Mərkəzi Bankda hesab edirlər ki, depozit gəlirlərində güzəştlərin ləğvindən sonra banklar həmin xərci öz depozit faizlərində əks etdirəcək. Yəni əmanət gəlirləri vergiyə cəlb olunduqda banklar depozit faizlərini artıracaq. Bank vətəndaşa daha çox dividend ödəyəcək ki, vergi çıxılandan sonra onun depozit gəliri azalmasın.
Mərkəzi Bankın özünün metodologiyasında da bank kreditlərinin faizlərinin yüksək olmasını depozitlərin bahalılığı ilə əlaqələndirilir. Deməli, depozit faizlərinin artması kreditlərin bahalaşmasına və bankların daha yüksək faizli kredit təklif etməsinə səbəb olacaq. Yəni əmanət gəlirlərinn vergiyə cəlb olunması ilə kreditlər bahalaşacaq”.
Qeyd edək ki, Azərbaycan Mərkəzi Bankının məlumatına görə, hazırda kredit portfeli 19 milyard 594 milyon manatdır. Ölkə üzrə orta kredit faizi 14,13 faizdir. Ən bahalı kreditlər isə (20,43 faiz) Mil-Muğan iqtisadi rayonundadır. Bu rəqəmlərin orta kredit faizləri olduğunu deyən V.Bayramov istehlak kreditlərinin daha yüksək faizlərlə verildiyini bildirib.
ENA.az Maliyyə Qrupu